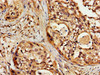

Cusabio Polyclonal Antibodies
SLC22A17 Antibody | CSB-PA823881LA01HU
- SKU:
- CSB-PA823881LA01HU
- Availability:
- 3 to 7 Working Days
Description
SLC22A17 Antibody | CSB-PA823881LA01HU | Cusabio
SLC22A17 Antibody is Available at Gentaur Genprice with the fastest delivery.
Online Order Payment is possible or send quotation to info@gentaur.com.
Product Type: Polyclonal Antibody
Target Names: SLC22A17
Aliases: Solute carrier family 22 member 17 (24p3 receptor) (24p3R) (Brain-type organic cation transporter) (Lipocalin-2 receptor) (Neutrophil gelatinase-associated lipocalin receptor) (NgalR), SLC22A17, BOCT BOIT
Background: Cell surface receptor for LCN2 (24p3) that plays a key role in iron homeostasis and transport. Able to bind iron-bound LCN2 (holo-24p3), followed by internalization of holo-24p3 and release of iron, thereby increasing intracellular iron concentration and leading to inhibition of apoptosis. Also binds iron-free LCN2 (apo-24p3), followed by internalization of apo-24p3 and its association with an intracellular siderophore, leading to iron chelation and iron transfer to the extracellular medium, thereby reducing intracellular iron concentration and resulting in apoptosis.
Isotype: IgG
Conjugate: Non-conjugated
Clonality: Polyclonal
Uniport ID: Q8WUG5
Host Species: Rabbit
Species Reactivity: Human
Immunogen: Recombinant Human Solute carrier family 22 member 17 protein (1-99AA)
Immunogen Species: Human
Applications: ELISA, WB, IHC, IF
Tested Applications: ELISA, WB, IHC, IF; Recommended dilution: WB:1:500-1:5000, IHC:1:100-1:500, IF:1:50-1:500
Purification Method: >95%, Protein G purified
Dilution Ratio1: ELISA:1:2000-1:10000
Dilution Ratio2: WB:1:500-1:5000
Dilution Ratio3: IHC:1:100-1:500
Dilution Ratio4: IF:1:50-1:500
Dilution Ratio5:
Dilution Ratio6:
Buffer: Preservative: 0.03% Proclin 300
Constituents: 50% Glycerol, 0.01M PBS, PH 7.4
Form: Liquid
Storage: Upon receipt, store at -20°C or -80°C. Avoid repeated freeze.
Initial Research Areas: Signal Transduction
Research Areas: Cancer;Metabolism;Signal transduction